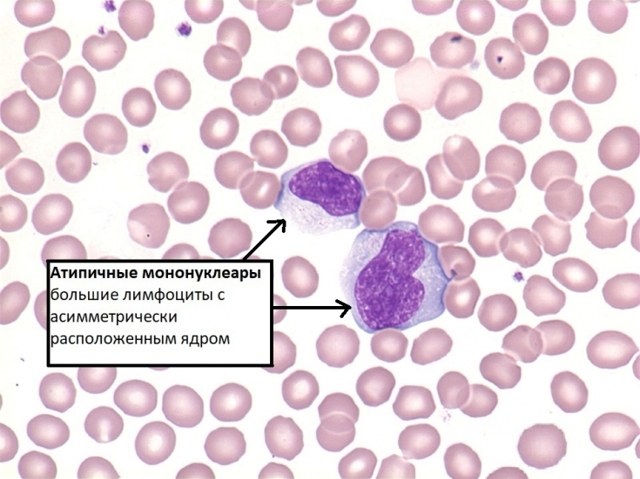

Общий анализ крови (ОАК) — важный инструмент для диагностики и мониторинга состояния пациентов с ВИЧ-инфекцией. Он выявляет изменения в составе крови, указывающие на прогрессирование заболевания и состояние иммунной системы. В статье рассмотрим показатели ОАК, значимые при подозрении на ВИЧ, их изменения на ранних стадиях инфекции и важность регулярного контроля для оценки эффективности терапии. Также будет представлена таблица нормальных значений и возможных отклонений, что поможет понять влияние ВИЧ на организм.
Зачем и когда нужен анализ крови при ВИЧ
ОАК – это стандартное исследование, которое ежегодно проходит множество пациентов. Его назначают в самых разных случаях, как для лечения, так и для профилактики. Исследования показывают, что ВИЧ может передаваться через кровь и во время половых контактов. При оценке рисков заражения важно учитывать все возможные пути передачи инфекции.
Ситуации, в которых может быть назначен ОАК:
- при плановых медицинских обследованиях;
- перед проведением хирургических операций – это помогает избежать потенциальных осложнений;
- после полового акта с ВИЧ-позитивным партнером;
- во время беременности – в этот период женщина проходит множество анализов, так как некоторые заболевания могут передаваться ребенку;
- для диагностики – это исследование помогает выявить болезни печени, почек и других внутренних органов;
- после татуировок и пирсинга в условиях, где не соблюдаются санитарные нормы.
Также на анализ направляют медицинских работников, которые контактируют с кровью пациентов, и доноров, так как они также могут подвергаться риску заражения.
Важно!
Чтобы избежать заражения ВИЧ у стоматолога, настаивайте на использовании одноразовых инструментов и вскрытии упаковки в вашем присутствии.
Анализ может быть назначен и при наличии следующих симптомов:
- резкое и необъяснимое снижение веса;
- постоянное чувство усталости и апатии;
- повышенная температура тела (+37,5°С) в течение месяца или дольше;
- ночное потоотделение;
- отсутствие аппетита;
- длительные и частые боли в мышцах;
- сыпь и язвы на коже и слизистых оболочках.
Вирус иммунодефицита, как и любое другое заболевание, влияет на количественные и качественные показатели анализируемых биоматериалов. При заражении наблюдаются изменения в показателях крови, мочи, слюны и других жидкостей. По результатам общего анализа крови можно оценить вероятность наличия ВИЧ у пациента. Однако ОАК не может однозначно подтвердить или опровергнуть наличие инфекции, но позволяет оценить состояние иммунной системы.
ВИЧ негативно влияет на иммунную систему, снижая ее эффективность, что сразу же отражается на показателях крови. ОАК – это простой и доступный метод скрининга, который позволяет разделить обследуемых на две группы: с подозрением на ВИЧ и условно здоровых.
https://youtube.com/watch?v=2G80HJlq-pI
Общий анализ крови является важным инструментом для оценки состояния здоровья пациентов с ВИЧ-инфекцией. Врачи отмечают, что при этом заболевании могут наблюдаться изменения в различных показателях крови. Например, уровень CD4-лимфоцитов, который отражает состояние иммунной системы, часто снижается, что указывает на прогрессирование инфекции. Кроме того, общий анализ может показать анемию, тромбоцитопению и лейкопению, что также свидетельствует о воздействии вируса на организм. Врачи подчеркивают, что регулярное проведение анализа позволяет отслеживать динамику заболевания и эффективность терапии, а также своевременно выявлять возможные осложнения. Таким образом, общий анализ крови играет ключевую роль в управлении ВИЧ-инфекцией и поддержании здоровья пациентов.
Преимущества ОАК при диагностике ВИЧ
Хотя общий анализ крови (ОАК) не способен с полной уверенностью подтвердить наличие вируса иммунодефицита, его значение трудно переоценить. Это исследование помогает выявить скрытые проблемы в организме и установить их причины.
Преимущества ОАК-скрининга:
- доступная цена;
- быстрота получения результатов;
- возможность выявления значительных изменений в показателях;
- простота и отсутствие болезненных ощущений.
Может ли общий анализ крови подтвердить заражение ВИЧ? Однозначно, нет. На основе результатов анализа врачи могут направить пациента на дальнейшее обследование, в ходе которого будет поставлен точный диагноз. Либо подозрение на ВИЧ может быть опровергнуто. Важно, чтобы в этот период человек с подозрением на ВИЧ не испытывал преждевременного психоэмоционального стресса.
https://youtube.com/watch?v=WDz7gLqrZYw
| Показатель общего анализа крови | Изменения при ВИЧ-инфекции | Возможные причины и значение |
|---|---|---|
| Гемоглобин | Снижение (анемия) | Подавление костного мозга вирусом, дефицит железа, хронические инфекции, побочные эффекты антиретровирусной терапии (АРВТ) |
| Эритроциты | Снижение (анемия) | Аналогично гемоглобину |
| Лейкоциты (общая численность) | Снижение (лейкопения) | Поражение костного мозга, оппортунистические инфекции, побочные эффекты АРВТ |
| Лимфоциты (общая численность) | Снижение (лимфопения) | Характерный признак ВИЧ-инфекции, особенно снижение CD4+ Т-лимфоцитов (хотя их количество не определяется в общем анализе крови) |
| Нейтрофилы | Снижение (нейтропения) | Подавление костного мозга, оппортунистические инфекции, побочные эффекты АРВТ |
| Тромбоциты | Снижение (тромбоцитопения) | Поражение костного мозга, аутоиммунные процессы, побочные эффекты АРВТ |
| СОЭ (скорость оседания эритроцитов) | Повышение | Воспалительные процессы, оппортунистические инфекции, лимфома |
Порядок забора крови и подготовка к нему
Забор крови можно осуществить в любой лаборатории поликлиники или в стационаре. Также существуют лаборатории, которые предлагают услугу выезда на дом для забора материала у пациента, что особенно удобно для тех, кому рекомендовано избегать физической активности.
Процедура забора крови обычно начинается с прокола безымянного пальца с помощью специального скарификатора — иглы, которая обеспечивает быстрый и менее болезненный прокол. Этот инструмент стерилен и предназначен для одноразового использования.
Кровь выдавливают из пальца легким нажатием и распределяют по нескольким пробиркам. Для детей и людей с низким болевым порогом рекомендуется использовать стерильные ланцеты с скрытыми микро-иглами для забора крови.
Чтобы результаты анализа были точными, пациенты должны следовать определенным правилам подготовки к общему анализу крови (ОАК):
- Ужин должен быть не позднее 20:00 накануне анализа.
- Вечером перед анализом следует исключить из рациона жареную и жирную пищу.
- Употребление алкоголя запрещено за три дня до анализа.
- В день забора крови утром не следует курить.
- За сутки до анализа необходимо избегать физических и эмоциональных нагрузок (рекомендуется сохранять спокойствие).
- Утром перед забором крови не допускаются любые манипуляции и процедуры (массаж, рентген, УЗИ, физиотерапия, любые инструментальные вмешательства).
- В течение двух недель перед анализом не рекомендуется принимать антибиотики и другие препараты, которые могут повлиять на результаты.
- Кровь сдают натощак, утром разрешается пить только воду, чай и кофе употреблять нельзя.
Обратите внимание!
Скарификатор должен быть стерильным и предназначен для одноразового использования. Он должен находиться в упаковке до момента вскрытия, которое происходит непосредственно перед забором крови.
Кровь для ОАК также можно взять из вены, однако этот метод более болезненный. Забор производится из локтевой вены: у правшей — из левой руки, у левшей — из правой. Если не удается взять кровь из локтевой вены, забор может быть выполнен из вен на тыльной стороне руки или стопе.
Отклонения в анализах при ВИЧ
Общий анализ крови (ОАК) не является специализированным методом для точной диагностики ВИЧ, однако он способен выявить некоторые признаки, указывающие на возможное наличие вируса. Результаты этого анализа могут сигнализировать о проблемах в иммунной системе, что создает основания для подозрений на вирус иммунодефицита.
Нормальные показатели ОАК:
| Параметры | Нормальные значения |
| Лейкоциты | 4-9 х 10^9/л |
| Гемоглобин | 130-170 г/л |
| Эритроциты | 4-5/3,5-4,7 х 10^12/л (для мужчин/женщин) |
| Тромбоциты | 180-320 х 10^9/л |
| СОЭ | 3-10/5-15 мм/ч (для мужчин/женщин) |
Изменения в показателях ОАК могут указывать на наличие иммунодефицита. В зависимости от того, повышены или понижены лейкоциты и другие параметры при ВИЧ-инфекции, специалисты могут, сравнивая нормальные значения с полученными результатами, сделать выводы о состоянии иммунной системы.

Лимфоциты
На начальных этапах ВИЧ наблюдается увеличение количества лимфоцитов, что называется лимфоцитозом. Это явление связано с активной реакцией иммунной системы на вирусную инфекцию.
С течением времени, по мере прогрессирования заболевания и ослабления иммунной защиты, происходит снижение уровня лимфоцитов. Данная патология известна как лимфопения. При ВИЧ обычно фиксируется уменьшение доли Т-лимфоцитов.
Характеристики и нормы показателей иммунограммы, интерпретация анализа. Человеческий организм постоянно подвергается воздействию внешней среды и взаимодействует с различными микроорганизмами,…
Мононуклеары
Мононуклеары — это одноядерные лимфоциты, которые являются одной из форм лейкоцитов. Присутствие этих атипичных клеток в крови может свидетельствовать о наличии инфекции в организме. Вызвать такую реакцию могут как вирусы, так и бактерии. У здорового человека мононуклеары в крови не обнаруживаются.
Нейтрофилы
Лейкоциты при ВИЧ проявляют различные реакции. На начальном этапе они активируются, стараясь противостоять вирусным клеткам. Нейтрофилы, являющиеся подтипом лейкоцитов (белых кровяных телец), участвуют в процессе фагоцитоза, пытаясь захватить вирус. Однако неравная борьба приводит к снижению уровня лейкоцитов по мере прогрессирования ВИЧ.
Когда количество нейтрофилов при ВИЧ уменьшается, врачи говорят о нейтропении. В норме содержание этих клеток составляет от 45 до 70%. Однако такая ситуация не является уникальной для ВИЧ; аналогичные изменения наблюдаются при любом инфекционно-воспалительном процессе.
Зачем сдают кровь на стерильность? Анализ крови на стерильность является одним из самых важных исследований для правильной диагностики пациентов с…
Эритроциты
Эти двояковыпуклые красные кровяные клетки, окрашенные благодаря содержанию гемоглобина, играют ключевую роль в организме. Они отвечают за транспортировку питательных веществ и кислорода к различным органам и тканям. Продолжительность жизни эритроцитов составляет около четырех месяцев, после чего они разрушаются, а в организме происходит их постоянное обновление.
Показатель уровня эритроцитов не всегда является надежным при диагностике у людей с возможным иммунодефицитом. Известно, что при СПИДе наблюдается снижение концентрации этих клеток. Это связано с тем, что вирус негативно воздействует на костный мозг, который отвечает за процесс кроветворения.
Тем не менее, бывают ситуации, когда при иммунодефиците уровень эритроцитов может увеличиваться. Обычно это происходит в случаях, когда ВИЧ сопровождается другими заболеваниями, такими как пневмония или туберкулез.
Тромбоциты
Тромбоциты формируются в костном мозге и разрушаются в селезенке и печени. Их количество играет ключевую роль в процессе свертывания крови. У людей, инфицированных ВИЧ, уровень этих клеток снижается, что приводит к ухудшению свертываемости. В результате у таких пациентов могут проявляться различные виды кровотечений как один из клинических признаков заболевания.
Важно знать!
Снижение уровня тромбоцитов у пациентов с ВИЧ может вызывать как внутренние, так и наружные кровотечения, появление мелкой кожной сыпи (петехий) и множественные кровоизлияния на слизистых оболочках.
Гемоглобин
Гемоглобин, представляющий собой соединение белка и железа, выполняет важную функцию – транспортировку кислорода. Низкий уровень гемоглобина у людей с ВИЧ является распространенной проблемой. Когда уровень Hb снижается, это может привести к серьезному состоянию – гипоксии, то есть нехватке кислорода в организме. При железодефицитной анемии страдают все органы и ткани.
Клиническую анемию можно определить по характерным признакам. У пациента наблюдаются постоянная слабость, бледность кожи и учащенное сердцебиение.
СОЭ
Скорость оседания эритроцитов (СОЭ) при ВИЧ может оставаться в пределах нормы на протяжении нескольких лет, а затем внезапно увеличиваться. Этот показатель не является достаточно информативным, и его нормальные значения не могут служить доказательством отсутствия иммунодефицита. Повышенная скорость оседания эритроцитов может свидетельствовать о наличии воспалительного процесса в организме. При этом рост СОЭ может наблюдаться как в начале воспаления, так и на его активной стадии. Высокие значения СОЭ также могут быть связаны с опухолевыми заболеваниями и интоксикациями, а у женщин этот показатель может увеличиваться во время менструаций.
Увеличение количества лейкоцитов в крови, которое наблюдается при ВИЧ, а также применение некоторых медикаментов, может привести к снижению СОЭ. В частности, противовоспалительные нестероидные и гормональные препараты способны вызывать падение этого показателя. Подозрение на наличие ВИЧ-инфекции возникает при значительном увеличении СОЭ, достигающем примерно 50 мм/ч.
Если ВИЧ обнаружен
Если общий анализ крови (ОАК) выявил результаты, которые могут свидетельствовать о наличии вируса иммунодефицита, пациенту рекомендуется пройти специализированное исследование для определения ВИЧ-статуса.
Исследования на ВИЧ:
- Иммуноферментный анализ (ИФА). Это метод исследования крови, основанный на иммунологической реакции. В образец (обычно венозную кровь) добавляют специфические антитела, чтобы определить уровень образовавшихся антитело-антигенных комплексов. На основе их концентрации можно сделать вывод о активности определенных соединений в образце. Этот анализ позволяет установить количество вирусных клеток и оценить состояние иммунной системы.
- Иммуноблот. Это исследование проводится после двух положительных результатов ИФА. Иммуноблоттинг считается более надежным методом и представляет собой комбинацию ИФА и электрофореза. Он помогает выявить антитела к конкретным антигенам. Исследование осуществляется с использованием специальных тест-полосок, на которых при обнаружении антител к определенному антигену появляется темная линия.
Сначала по результатам общего анализа крови можно заподозрить ВИЧ, так как наблюдаются отклонения от нормальных показателей. В дальнейшем пациенту необходимо регулярно сдавать анализы на показатели крови, что позволяет контролировать его здоровье при ВИЧ.
Если у пациента обнаружен ВИЧ, его сразу направляют на дополнительные анализы для выявления других инфекций, таких как туберкулез, кандидоз, малярия и менингит. Из-за ослабленного иммунитета инфицированный может легко подхватить различные инфекции, включая герпес и токсоплазмоз.
Основные показатели контроля:
- вирусная нагрузка – изменения в этом показателе помогают оценить прогрессирование синдрома иммунодефицита;
- количество CD4 и соотношение CD4/CD8 (гликопротеины, ключевые клетки иммунной системы) – позволяет оценить изменения в иммунной системе инфицированного.
Важно знать!
Референсное значение соотношения CD4/CD8 у здорового человека составляет 1,6-2,2.
Пациенты с ВИЧ регулярно проходят биохимический анализ крови, анализ мочи и различные общеклинические исследования. Это помогает своевременно выявить осложнения, сопутствующие заболевания и побочные эффекты от приема противовирусных препаратов.
Хотя ОАК не может с 100%-ной точностью подтвердить наличие ВИЧ или определить его стадию, он может стать важным сигналом для дальнейшего обследования. Если хотя бы один из показателей крови отклоняется от нормы, необходимо выяснить причину этого, и если у пациента есть ВИЧ, он будет выявлен. Чем раньше начнется лечение, тем выше шансы на долгую и качественную жизнь.

Роль общего анализа крови в мониторинге состояния пациента
Общий анализ крови (ОАК) является одним из основных лабораторных исследований, используемых для оценки состояния здоровья пациента. При ВИЧ-инфекции он играет ключевую роль в мониторинге иммунного статуса и общего состояния организма. ВИЧ (вирус иммунодефицита человека) поражает иммунную систему, что может привести к различным изменениям в составе крови, которые можно выявить с помощью ОАК.
Одним из главных показателей, на который обращают внимание при анализе крови, является уровень CD4-лимфоцитов. Эти клетки играют важную роль в иммунном ответе организма. Нормальный уровень CD4-лимфоцитов составляет от 500 до 1600 клеток на микролитр крови. При ВИЧ-инфекции количество CD4-лимфоцитов может значительно снижаться, что указывает на прогрессирование заболевания и ослабление иммунной системы. ОАК позволяет отслеживать динамику этого показателя, что важно для выбора терапии и оценки ее эффективности.
Кроме CD4-лимфоцитов, общий анализ крови также позволяет оценить уровень гемоглобина, количество эритроцитов и тромбоцитов. У пациентов с ВИЧ-инфекцией может наблюдаться анемия, которая возникает из-за различных факторов, включая вирусное воздействие, сопутствующие инфекции и побочные эффекты антиретровирусной терапии. Снижение уровня гемоглобина может указывать на необходимость коррекции лечения или дополнительного обследования.
Тромбоциты также являются важным показателем. Их уровень может снижаться при ВИЧ-инфекции, что увеличивает риск тромбообразования и кровотечений. ОАК позволяет своевременно выявить такие изменения и принять меры для их коррекции.
Важно отметить, что общий анализ крови не только помогает в диагностике и мониторинге ВИЧ-инфекции, но и позволяет выявлять сопутствующие заболевания и инфекции, которые могут возникать на фоне ослабленного иммунитета. Например, изменения в лейкоцитарной формуле могут указывать на наличие бактериальных или вирусных инфекций, что требует немедленного вмешательства.
Таким образом, общий анализ крови является незаменимым инструментом в управлении ВИЧ-инфекцией. Он предоставляет важную информацию о состоянии иммунной системы, позволяет отслеживать эффективность лечения и выявлять возможные осложнения, что в конечном итоге способствует улучшению качества жизни пациентов.
Сравнение ОАК с другими методами диагностики ВИЧ
Общий анализ крови (ОАК) является одним из основных методов лабораторной диагностики, который позволяет оценить общее состояние организма и выявить различные патологии. При подозрении на ВИЧ-инфекцию ОАК может предоставить важную информацию о состоянии иммунной системы пациента, однако его результаты не могут служить единственным основанием для диагностики ВИЧ.
В отличие от специфических тестов на ВИЧ, таких как иммуноферментный анализ (ИФА) или полимеразная цепная реакция (ПЦР), ОАК не позволяет непосредственно выявить вирус или антитела к нему. Тем не менее, результаты общего анализа крови могут косвенно указывать на наличие инфекции, особенно на более поздних стадиях заболевания.
При ВИЧ-инфекции могут наблюдаться изменения в различных показателях ОАК. Например, снижение уровня CD4+ Т-лимфоцитов, которые являются ключевыми клетками иммунной системы, может быть отражено в показателях общего анализа крови. Это снижение может привести к уменьшению общего числа лейкоцитов, что указывает на ослабление иммунного ответа организма.
Также при ВИЧ-инфекции может наблюдаться анемия, которая проявляется снижением уровня гемоглобина и гематокрита. Анемия может быть вызвана как самим вирусом, так и сопутствующими инфекциями или побочными эффектами антиретровирусной терапии. Важно отметить, что анемия является распространенным состоянием у пациентов с ВИЧ и может значительно ухудшать качество жизни.
Кроме того, общий анализ крови может показать изменения в уровне тромбоцитов. У некоторых пациентов с ВИЧ наблюдается тромбоцитопения, что может быть связано с вирусной инфекцией или аутоиммунными процессами. Эти изменения могут указывать на необходимость более детального обследования и мониторинга состояния пациента.
Сравнивая ОАК с другими методами диагностики ВИЧ, можно отметить, что специфические тесты, такие как ИФА и ПЦР, имеют более высокую чувствительность и специфичность. Они позволяют не только подтвердить наличие вируса, но и определить его количество в крови, что является важным для оценки стадии заболевания и выбора тактики лечения.
Таким образом, общий анализ крови может служить вспомогательным инструментом в диагностике ВИЧ-инфекции, предоставляя информацию о состоянии иммунной системы и возможных сопутствующих заболеваниях. Однако для точной диагностики и мониторинга ВИЧ-инфекции необходимо использовать более специфические методы, которые обеспечивают надежные результаты и позволяют врачам принимать обоснованные решения о лечении и наблюдении за пациентом.
Влияние сопутствующих заболеваний на результаты ОАК при ВИЧ
Общий анализ крови (ОАК) является одним из основных лабораторных исследований, позволяющих оценить состояние организма и выявить различные патологии, в том числе и при ВИЧ-инфекции. Однако результаты ОАК могут значительно варьироваться в зависимости от наличия сопутствующих заболеваний, которые могут оказывать влияние на иммунный статус пациента и общее состояние его здоровья.
При ВИЧ-инфекции иммунная система человека подвергается серьезным изменениям, что может привести к различным сопутствующим заболеваниям, таким как туберкулез, гепатиты, грибковые инфекции и другие. Эти заболевания могут оказывать влияние на показатели общего анализа крови, что важно учитывать при интерпретации результатов.
Одним из наиболее заметных изменений в ОАК при наличии сопутствующих заболеваний является изменение уровня лейкоцитов. Например, при бактериальных инфекциях может наблюдаться лейкоцитоз (увеличение количества лейкоцитов), тогда как при вирусных инфекциях, включая ВИЧ, может наблюдаться лейкопения (снижение уровня лейкоцитов). Это может затруднить диагностику и мониторинг состояния пациента, так как изменения в лейкоцитарной формуле могут быть связаны как с ВИЧ, так и с сопутствующими инфекциями.
Кроме того, сопутствующие заболевания могут влиять на уровень тромбоцитов. У пациентов с ВИЧ-инфекцией и сопутствующими заболеваниями, такими как гепатит, может наблюдаться тромбоцитопения (снижение уровня тромбоцитов), что увеличивает риск тромбообразования и геморрагий. Это также может затруднить лечение, так как некоторые препараты, используемые для терапии ВИЧ, могут дополнительно снижать уровень тромбоцитов.
Гемоглобин и гематокрит также могут изменяться под воздействием сопутствующих заболеваний. Например, у пациентов с ВИЧ и хроническими заболеваниями печени может развиваться анемия, что отразится на показателях общего анализа крови. Анемия может быть связана как с недостатком железа, так и с нарушением синтеза эритроцитов, что требует дополнительного обследования и коррекции лечения.
Важно отметить, что при интерпретации результатов ОАК у пациентов с ВИЧ необходимо учитывать не только наличие сопутствующих заболеваний, но и их стадию, а также текущее лечение. Например, некоторые антиретровирусные препараты могут оказывать влияние на показатели крови, что также следует учитывать при анализе результатов.
Таким образом, общий анализ крови является важным инструментом для мониторинга состояния пациентов с ВИЧ-инфекцией, однако его результаты могут быть искажены наличием сопутствующих заболеваний. Поэтому для точной диагностики и эффективного лечения необходимо проводить комплексное обследование и учитывать все возможные факторы, влияющие на результаты анализа.